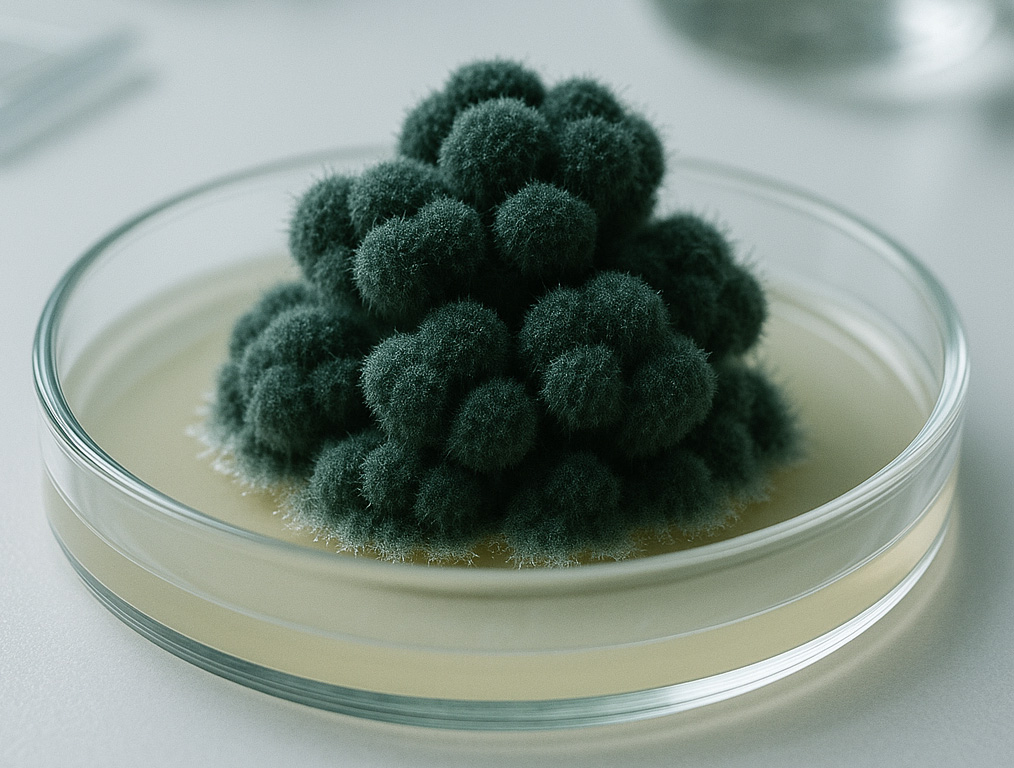

Descoperirea care ar putea proteja astronauții în spațiu
Cercetătorii au descoperit un fenomen uimitor în ruinele reactorului 4 de la Cernobîl: un tip de mucegai negru pare să crească mai bine în prezența radiațiilor, ba chiar ar putea transforma energia ionizantă în „combustibil” pentru dezvoltarea lui. Descoperirea, deși pare desprinsă dintr-un film SF, ar putea avea aplicații uriașe — de la curățarea zonelor radioactive până la protejarea astronauților în misiuni pe Lună sau Marte.
O descoperire făcută în inima celei mai radioactive clădiri din lume
În 1997, cercetătoarea ucraineană Nelli Zhdanova a intrat în interiorul reactorului explodat de la Cernobîl și a observat ceva neașteptat: pe pereți, pe plafon și în canalele metalice care protejau cablurile electrice creștea un mucegai negru compact. Nu era acolo doar pentru că oamenii plecaseră. Ci părea atras de radiații.
Zhdanova remarcase deja, în analizele din solul din jurul centralei, că aceste ciuperci se dezvoltau în direcția particulelor radioactive. Când a descoperit că pătrunseseră chiar în camerele unde se aflase miezul reactorului, intuiția ei a devenit clară: ciupercile nu doar supraviețuiau radiațiilor — le căutau activ.
Fenomenul a primit un nume: radiotropism.
Cum pot ciupercile să crească într-un mediu letal? Răspunsul: melanina
Mucegaiul negru observat la Cernobîl conține în pereții celulari cantități mari de melanină – același pigment care dă culoarea pielii și părului la oameni. Dacă melanina ne protejează de radiațiile ultraviolete, în cazul acestor ciuperci pare să joace un rol mult mai spectaculos:
✔️ le protejează împotriva radiațiilor ionizante
✔️ le ajută să neutralizeze moleculele reactive create de radiație
✔️ ar putea transforma energia radiației în energie biologică
Cu alte cuvinte, ciupercile folosesc radiația ca sursă de energie — exact cum plantele folosesc lumina solară. Procesul propus de cercetători a fost numit „radiosinteză”.
Deocamdată, este o teorie, dar mai multe experimente o susțin.
Ciuperci care cresc mai repede în radiație
În 2007, cercetătoarea Ekaterina Dadachova, de la Colegiul de Medicină Albert Einstein din New York, a testat mucegaiuri similare în prezența izotopului radioactiv cesiu-137. Rezultatul:
ciupercile melanizate creșteau cu 10% mai repede când erau expuse la radiații decât atunci când erau crescute în condiții normale.
Mai mult, păreau să transforme energia radiației în procese metabolice. Era exact ceea ce Zhdanova sugerase: organisme care „se hrănesc” din radiații.
Testul suprem: spațiul cosmic
În 2018, specia Cladosporium sphaerospermum, aceeași descoperită de Zhdanova la Cernobîl, a fost trimisă pe Stația Spațială Internațională (ISS). Rezultatele au fost surprinzătoare:
- ciuperca a crescut cu 21% mai repede în spațiu decât pe Pământ
- radiația cosmică, extrem de puternică, părea să fie absorbită eficient de biomasa fungică
- un strat subțire de mucegai reducea radiațiile măsurate de senzorii ISS
Cu toate acestea, oamenii de știință nu sunt încă siguri dacă radiația cosmică sau microgravitația au dus la creșterea accelerată. Experimentele continuă.
Protecția astronauților: un perete din ciuperci în jurul lor?
Radiațiile cosmice sunt considerate „cel mai mare pericol pentru explorarea umană a spațiului”.
Pe Pământ suntem protejați de atmosferă și magnetosferă, dar în spațiu, și mai ales pe Lună sau Marte, expunerea este continuă și extrem de periculoasă. Materialele folosite în mod obișnuit pentru protecție – apă, plastic, metal – sunt eficiente, dar foarte grele, ceea ce le face costisitoare pentru transportul în spațiu.
De aceea, NASA și alte agenții iau în calcul o alternativă revoluționară: pereți și structuri construite din fungi melanizați, care absorb radiațiile și se pot regenera singuri.
Arhitectura bazată pe ciuperci, numită „myco-architecture”, ar putea:
- reduce enorm costurile misiunilor
- crea locuințe care cresc direct pe Lună sau Marte
- oferi protecție naturală împotriva radiațiilor
- se repare singure în timp
De la Cernobîl la Lună: un drum neașteptat
Ceea ce a început ca un studiu de ecologie într-o zonă contaminată a ajuns să rescrie idei fundamentale despre viața pe Pământ. Dacă se confirmă că unele ciuperci pot transforma radiația în energie, aceasta ar putea fi o formă de metabolism necunoscută până acum.
Și poate, peste câteva decenii, exact mucegaiul negru care a colonizat ruinele Cernobîlului ar putea proteja primele baze umane de pe Lună sau din adâncurile spațiului.
Cercetările continuă, dar promisiunea este uriașă:
o biologie care nu se teme de radiație, ci o transformă în resursă, poate deveni cheia explorării umane a altor lumi.
01/11/2025
Scris de Adrian Stoica
Sursa BBC



